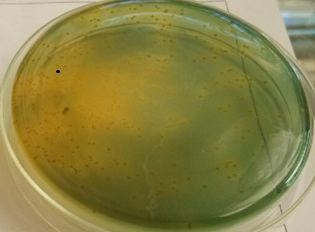
使用前有大量弧菌
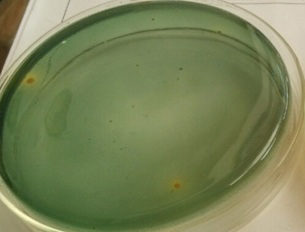
使用后弧菌明显减少

一、养殖户信息
养殖户姓名:胡老板 联系方式:152****7499
养殖品种:南美白对虾 养殖面积:20亩
养殖模式:鱼虾混养 塘口位置:灌南堆沟港镇
二、问题阐述
6月18日上午,胡老板塘口水质检测指标检测如下pH 8.4,氨氮0,亚盐0,透明度20cm,水质清爽,但虾吃料减少,贴边游塘,不久便死亡。检查虾肝胰腺正常,肠道正常,镜检甲壳有白斑。
三、 问题诊断
做弧菌实验有不少弧菌,初步诊断为细菌感染所致,加之虾缺乏营养,经过暴雨应激引起死亡。
四、 处理方案
1、6月19日上午使用“多联噬菌王”全塘泼洒,1瓶2亩,捕食裂解有害细菌,消灭弧菌,改善养殖环境。
2、6月21日上午使用“六黄神露”(1瓶3亩)+“免疫肝胆宝”(1瓶3亩)兑水全塘泼洒,清凉解毒,护鳃护肠护肝。免疫肝胆宝,保肝利胆,保护肝细胞,减轻肝脏负担;免疫促长,促进矿物质、微量元素的消化吸收和体内血液循环。隔天再用一遍。
五、处理结果
使用前
使用前
使用后
使用后
6月26日跟踪服务,弧菌明显减少,白对虾死亡止住,吃料恢复,为防止突发情况,使用 “免疫肝胆宝”+“免疫多糖”拌料投喂。提高机体抗应激、抗诱变、抗病源微生物的内源力,增强机体免疫力,促进生长,增强食欲。
六、小结
随着天气的变化,弧菌等很容易繁殖起来,引起虾的各种病症,经常使用绿科微生物,以菌抑菌,达到防控的目的。